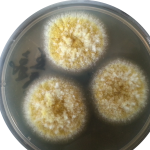
Aspergillus flavus

Collection Group: Mycology
Nigrosin Preparation Showing Cryptococcus Capsule: Introduction, Preparation and Result Interpretation
 Cryptococcus capsule in Nigrosin Nigrosin preparation-Positive with the following characteristics-...
Cryptococcus capsule in Nigrosin Nigrosin preparation-Positive with the following characteristics-...
Aspergillus flavus on Czapek Dox Agar: Introduction and Colony Morphology
 Introduction Aspergillus flavus on Czapek Dox agar Aspergillus flavus growth on Czapek...
Introduction Aspergillus flavus on Czapek Dox agar Aspergillus flavus growth on Czapek...
Aspergillus flavus: Introduction, Pathogenecity, Laboratory Diagnosis and Treatment
Introduction of Aspergillus flavus Aspergillus flavus on Czapek- Dox agar...
Introduction of Aspergillus flavus Aspergillus flavus on Czapek- Dox agar...
